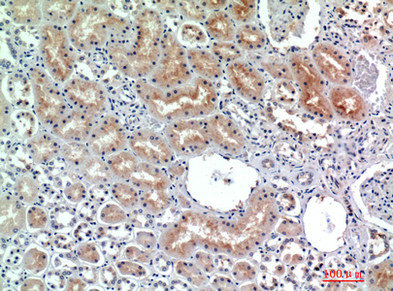

DPP4 Antibody
-
中文名稱:DPP4兔多克隆抗體
-
貨號:CSB-PA830019
-
規格:¥1090
-
圖片:
-
其他:
產品詳情
-
Uniprot No.:
-
基因名:
-
別名:DPP4; ADCP2; CD26; Dipeptidyl peptidase 4; ADABP; Adenosine deaminase complexing protein 2; ADCP-2; Dipeptidyl peptidase IV; DPP IV; T-cell activation antigen CD26; TP103; CD antigen CD26
-
宿主:Rabbit
-
反應種屬:Human
-
免疫原:Synthesized peptide derived from the Internal region of Human CD26.
-
免疫原種屬:Homo sapiens (Human)
-
標記方式:Non-conjugated
-
純化方式:The antibody was affinity-purified from rabbit antiserum by affinity-chromatography using epitope-specific immunogen.
-
濃度:It differs from different batches. Please contact us to confirm it.
-
保存緩沖液:Liquid in PBS containing 50% glycerol, 0.5% BSA and 0.02% sodium azide.
-
產品提供形式:Liquid
-
應用范圍:WB, IHC, ELISA
-
推薦稀釋比:
Application Recommended Dilution WB 1:500-1:2000 IHC 1:100-1:300 ELISA 1:10000 -
Protocols:
-
儲存條件:Upon receipt, store at -20°C or -80°C. Avoid repeated freeze.
-
貨期:Basically, we can dispatch the products out in 1-3 working days after receiving your orders. Delivery time maybe differs from different purchasing way or location, please kindly consult your local distributors for specific delivery time.
-
用途:For Research Use Only. Not for use in diagnostic or therapeutic procedures.
相關產品
靶點詳情
-
功能:Cell surface glycoprotein receptor involved in the costimulatory signal essential for T-cell receptor (TCR)-mediated T-cell activation. Acts as a positive regulator of T-cell coactivation, by binding at least ADA, CAV1, IGF2R, and PTPRC. Its binding to CAV1 and CARD11 induces T-cell proliferation and NF-kappa-B activation in a T-cell receptor/CD3-dependent manner. Its interaction with ADA also regulates lymphocyte-epithelial cell adhesion. In association with FAP is involved in the pericellular proteolysis of the extracellular matrix (ECM), the migration and invasion of endothelial cells into the ECM. May be involved in the promotion of lymphatic endothelial cells adhesion, migration and tube formation. When overexpressed, enhanced cell proliferation, a process inhibited by GPC3. Acts also as a serine exopeptidase with a dipeptidyl peptidase activity that regulates various physiological processes by cleaving peptides in the circulation, including many chemokines, mitogenic growth factors, neuropeptides and peptide hormones such as brain natriuretic peptide 32. Removes N-terminal dipeptides sequentially from polypeptides having unsubstituted N-termini provided that the penultimate residue is proline.; (Microbial infection) Acts as a receptor for human coronavirus MERS-CoV-2.
-
基因功能參考文獻:
- Our results showed 14% inferior plasma DPP-4 activity in adolescent idiopathic scoliosis (AIS) patients when compared to healthy controls . Similarly, osteoblasts derived from AIS subjects had lower DPP-4 gene and protein expression than controls by 90.5% and 57.1% respectively (P < 0.009). DPP-4 expression was regulated in a different manner in osteoblasts isolated from AIS participants compared to controls. PMID: 28600546
- Here we review the recent advances in identifying the cellular sources of both circulating and membrane-bound DPP4 important for cleavage of the incretin hormones and regulation of glucose and lipoprotein metabolism. PMID: 29412815
- DPP4 activity when compared to healthy controls. Analysis of Dpp4-Liv-Tg mice revealed elevated systemic DPP4 activity and diminished active GLP-1 levels. PMID: 29031724
- DPP4 was not different in this group of polycystic ovarian syndrome patients. However, a relationship between DPP4 and markers of insulin resistance were found. PMID: 29680519
- The analysis of their molecular properties allowed the design of a multiple linear regression model for activity prediction. Their docking analysis allowed visualization of the interactions between the pharmacophore regions and hDDP-IV. PMID: 28027711
- The level of myocardial CD26 expression might be a predictive marker of prognosis in patients with heart failure. PMID: 30369565
- Our study showed that complement was excessively activated in MERS-CoV-infected hDPP4-Tg mice through observations of increased concentrations of the C5a and C5b-9 complement activation products in sera and lung tissues, respectively. PMID: 29691378
- API was demonstrated to inhibit the migration/invasion of NSCLC cells harboring different EGFR statuses via suppressing the Snail/Slug-mediated EMT..CD26 may be a useful biomarker for predicting NSCLC progression. API effectively suppressed lung cancer progression by targeting the CD26-Akt-Snail/Slug signaling pathway PMID: 30134935
- hepatocyte DPP4 promotes visceral adipose tissue inflammation and insulin resistance in obesity, and targeting this pathway may have metabolic benefits that are distinct from those observed with oral DPP4 inhibitors PMID: 29562231
- this study shows that CD26 expression is down-regulated on CD8(+) T cells in patients with Hashimoto's thyroiditis PMID: 29175506
- Several isoforms of DPP-IV and FAP are present in glioblastoma tissue. The absence of alkaline isoforms of both enzymes in glioma cell lines however suggests that isoforms from other, most likely stromal, cell types contribute to the overall pattern seen in glioblastoma tissues. PMID: 28452380
- Data suggest that dipeptidyl peptidase 4 (DPPIV) gene polymorphism influences disease susceptibility and acute pancreatitis (AP) severity. PMID: 28902797
- High levels of DPP4a are independently associated with an increased rate of no-reflow events. PMID: 28000723
- DPP-4 activity and GLP-1total levels were higher in patients with microvascular complications associated with T2DM. Contrary to expectations, no negative correlation was seen between GLP-1 and DDP-4 levels. This result suggests the possible inefficacy of DDP-4 activity as a marker to predict in vivo degradation of endogenous GLP-1. PMID: 29061224
- The study showed that DPP-4 inhibitor use does not modify the risk of bone fracture compared with placebo or other anti-diabetic medications in patients with type 2 diabetes. PMID: 27384445
- A close connection between SerpinB3 and DPPPIV has been identified, but further studies are required to better understand the mechanism by which these proteins communicate and exert metabolic effects in hepatocellular carcinoma. PMID: 29524519
- There is a U-shaped association of serum DPP-IV with mortality in chronic heart failure patients. PMID: 28318663
- Levels of DPPIV enzyme activity in sera of patients with psoriatic pruritus were significantly increased compared to those of healthy controls. PMID: 28365081
- These findings implicate that DPP4 plays a role in the aggressiveness of UCs, and can serve as a novel prognostic marker and therapeutic target. PMID: 27936466
- Data suggest that up-regulation of serum DPP4 activity is associated with severity of diabetic nephropathy/renal insufficiency/albuminuria in subjects with type 1 diabetes. PMID: 27625045
- DPPIV overexpression altered cell morphology and stimulated cell proliferation, invasion and tumorigenesis in endometrial carcinoma cells. PMID: 28060721
- MERS-CoV S protein binds to DPP4 to suppress macrophage activation via induction of IRAK-M, PPARgamma and the immunosuppressive cytokine IL-10. PMID: 28118607
- DPP4a may be associated with future major adverse cardiac or cerebrovascular events in diabetic STEMI patients. PMID: 28587613
- DPP4 inhibitors have been demonstrated to be beneficial in the improvement of endothelial homeostasis. PMID: 28440488
- As for 18Lin(-), CD34(-) HSCs are characterized by low expression of the tetraspanin CD9, which promotes homing, and high expression of the peptidase CD26, which inhibits homing. PMID: 28687990
- suggests that DPP4 T-molecules have modified binding and functions compared with their FL counterparts and may serve regulatory roles in normal and malignant hematopoiesis PMID: 28344320
- Analysis of both the structures and inhibitory activities suggests that the binding of the trifluorophenyl moiety in the S1 pocket and the piperazine-2-one moiety have hydrophobic interactions with Phe357 in the S2 extensive subsite, and that the multiple hydrogen bonds made by the (R)-beta-amine group in the S2 pocket and the contacts made by the (R)-tert-butyl group with Arg125 contribute to the high potency observed... PMID: 29061303
- the selective expression of DPP4 on the surface of senescent cells enables their preferential elimination. PMID: 28877934
- Study shows that increased DPP4 activities are independently associated with mild cognitive impairment in elderly patients with type 2 diabetes. PMID: 27371673
- A common variant, i.e., single nucleotide polymorphism rs6741949, in the DPP4 gene interacts with body adiposity and negatively affects glucose-stimulated GLP-1 levels, insulin secretion, and glucose tolerance. PMID: 28750074
- CUX-1 overexpression enhanced TNF- production on sCD26/LPS stimulation, while CUX-1 depletion had no effect. Neither CUX-1 overexpression nor CUX-1 depletion had an effect on IL-6 stimulation. These results are discussed in the context of a model that describes the mechanisms by which stimulation of monocytic cells by sCD26 and LPS leads to elevation of TNF- and IL-6 expression. PMID: 23805228
- Increased plasma DPP-4 activity may correlate with aneurysmal development. CD26 on monocytes plays a critical role in cell differentiation, possibly mediated by extracellular signal-regulated protein kinase 1/2-p21 axis signaling pathways and cytoskeletal proteins reassembly. PMID: 27887857
- Plasma DPP4 activity is significantly associated with NAFLD. The underlying mechanisms may be partly attributed to the interactions between insulin resistance, oxidative stress, inflammation, and DPP4. PMID: 28637594
- CD26+ fibroblasts possess proliferation advantage in comparison to CD26- fibroblasts, and the advantage caused expansion of CD26 positive fibroblast population promotes keloid progression. PMID: 28454879
- MFSD2B, CCL20 and STAT1, or STARD7 and ZNF512 genes may be risk or protect factors in prognosis of ADC; HTR2B, DPP4, and TGFBRAP1 genes may be risk factors in prognosis of SQC. PMID: 27301951
- Increased DPP4 expression is associated with cellular invasion and more aggressive disease in papillary thyroid cancer. DPP4 silencing or treatment with DPP4 inhibitors significantly suppressed colony formation, cell migration, and invasion. PMID: 28575350
- Cultured human skin fibroblasts displayed significantly higher levels of CD26 than gingival fibroblasts. This was associated with an increased expression of profibrotic genes and transforming growth factor-beta signaling in skin fibroblasts. PMID: 28641076
- Suggest DPP-4 inhibition has a neutral effect on cardiovascular risk in type 2 diabetics without a history of heart failure or renal insufficiency. PMID: 28145158
- To clarify whether DPP4 alters its general or partial structure according to the inhibitor used and whether DPP4 has a common rule for inhibitor binding, this study comprehensively analyzed X-ray cocrystal structures of DPP-4 and its inhibitor. All the main and side chains in the inhibitor binding area were minimally altered, except for a few side chains, despite binding to inhibitors of various shapes. PMID: 27491540
- DPP-4-dependent insulin like growth factor-1 inhibition in valvular interstitial cells contributes to aortic calcification. PMID: 28179397
- Data suggest that, in obesity, serum levels of active GLP1 are down-regulated and serum levels of soluble DPP4 are up-regulated; DPP4 levels correlate negatively with active GLP-1 levels but are positively associated with insulin resistance; thus, DPP4 may be biomarker for insulin resistance. This study was conducted in Malaysia. (GLP1 = glucagon-like peptide 1; DPP4 = dipeptidyl peptidase 4) PMID: 28288852
- YS110 is a humanised IgG1 monoclonal antibody with high affinity to the CD26 antigen. YS110 demonstrated preclinical anti-tumour effects without significant side effects PMID: 28291776
- Gain of CD26 expression on the malignant T-cells in relapsed erythrodermic leukemic mycosis fungoides PMID: 28083948
- like AprA, DPPIV is a chemorepellent for, and inhibits the proliferation of, D. discoideum cells, and that AprA binds some DPPIV binding partners such as fibronectin. PMID: 28028841
- CD26 expression should be incorporated in B-CLL patients risk assessment along with well known prognostic factors, since it seems to have a relationship with the tumor mass and influences TTT. PMID: 27376546
- Serum CD26 concentration might be an independent prognostic indicator in patients with esophageal squamous cell carcinoma . It might be also useful to detect recurrent tumor in postoperative patients. PMID: 27664490
- The trimeric form receptor-binding domain of MERS-CoV spike protein protected hDPP4 transgenic mice from lethal MERS-CoV challenge. PMID: 27750111
- Data suggest that dipeptidyl-peptidase 4 [DPP-4) induces a selective pathway of insulin resistance with reduced glycogen storage, enhanced glucose output and increased lipid accumulation in the liver. PMID: 28213130
- Analysis of human liver biopsy specimens revealed a correlation of DPP4 expression and DNA methylation to stages of hepatosteatosis and nonalcoholic steatohepatitis. PMID: 27999105
- The study suggests that a genetic interaction between DPP4 and CCR6 is involved in RA susceptibility PMID: 27587881
顯示更多
收起更多
-
亞細胞定位:[Dipeptidyl peptidase 4 soluble form]: Secreted.; Cell membrane; Single-pass type II membrane protein. Apical cell membrane; Single-pass type II membrane protein. Cell projection, invadopodium membrane; Single-pass type II membrane protein. Cell projection, lamellipodium membrane; Single-pass type II membrane protein. Cell junction. Membrane raft.
-
蛋白家族:Peptidase S9B family, DPPIV subfamily
-
組織特異性:Expressed specifically in lymphatic vessels but not in blood vessels in the skin, small intestine, esophagus, ovary, breast and prostate glands. Not detected in lymphatic vessels in the lung, kidney, uterus, liver and stomach (at protein level). Expressed
-
數據庫鏈接:
Most popular with customers
-
-
YWHAB Recombinant Monoclonal Antibody
Applications: ELISA, WB, IHC, IF, FC
Species Reactivity: Human, Mouse, Rat
-
Phospho-YAP1 (S127) Recombinant Monoclonal Antibody
Applications: ELISA, WB, IHC
Species Reactivity: Human
-
-
-
-
-